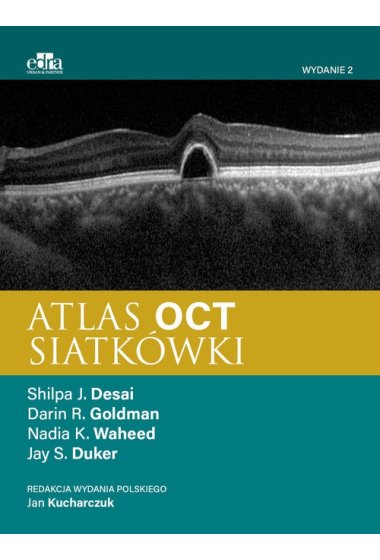

| Autor: | Duker J.S., Desai S.J. |
| Wydawnictwo: | Edra Urban & Partner |
| Kod: | 32891B03649KS |
| ISBN: | 9788368090604 |
| Format: | 21.0x27.5cm |
| Ilość stron: | 280 |
Atlas OCT siatkówki
Atlas OCT siatkówki, Duker J.S., Desai S.J.
Optyczna koherentna tomografia (OCT), nieoceniona pomoc w diagnozowaniu chorób siatkówki i rejestrowaniu postępu choroby, pozostaje jednym z najważniejszych osiągnięć w okulistyce w ciągu ostatnich 50 lat. Publikacja jest nieocenionym źródłem wiedzy przede wszystkim dla praktykujących lekarzy okulistów, którzy poszukują aktualnej i rzetelnej wiedzy na temat metod obrazowania schorzeń siatkówki. Można w niej znaleźć wiele najnowszych informacji i opisów zaawansowanych narzędzi diagnostycznych wspierających proces podejmowania decyzji klinicznych. Z pewnością okaże się pomocna także lekarzom rezydentom, podejmującym pracę na oddziałach okulistycznych, oraz młodym lekarzom na stażu podyplomowym. Ponad tysiąc szczegółowych, precyzyjnych, wysokiej jakości obrazów z badań OCT umożliwiających eliminowanie wszelkich wątpliwości diagnostycznych, interpretację wyników, trafną diagnostykę patologii i podejmowanie skutecznych decyzji dotyczących leczenia; Najbardziej aktualna wiedza i standardy praktyki dotyczące badania OCT; Przypadki schorzeń – często występujących i rzadkich; Wypunktowania i zwięzłe podsumowania ważnych cech każdej choroby, umożliwiające szybkie odnalezienie potrzebnych w gabinecie okulistycznym i klinice informacji.
Edra Urban & Partner
Kościuszki 29
50-011 Wrocław
Polska
| Firma kurierska | 0 zł |
| DPD Pickup punkt odbioru/ automat paczkowy | od 9.99 zł |
| InPost Paczkomat 24/7 | od 13 zł |
| Firma kurierska DHL | od 14 zł |
| Kurier DPD | od 14 zł |
| Kurier Inpost | od 14 zł |
| Punkt DHL Parcelshop | od 14 zł |
| Darmowa dostawa | od 159 zł |
Brak ocen.
Bądź pierwszy i dodaj opinię.